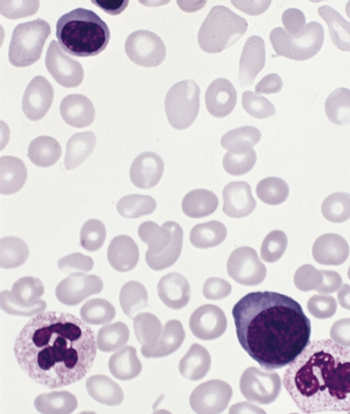

New research has identified specific gene mutations that occur in precancerous esophageal lesions, a finding which was then put into use with a simple non-endoscopic test.

New research has identified specific gene mutations that occur in precancerous esophageal lesions, a finding which was then put into use with a simple non-endoscopic test.

Colorectal cancer patients with higher levels of plasma vitamin D have better survival outcomes, according to a new prospective study.

Lymphocyte infusions are extremely effective therapy in patients with chronic myeloid leukemia who relapse after allogeneic hematopoietic stem cell transplantation, and the timing of the infusion is relatively unimportant, according to a new study.

Brachytherapy did not reduce rates of local recurrence after sublobar resection in patients with non–small-cell lung cancer, according to results of a new study.

Neoadjuvant chemoradiotherapy did not improve resection rates or survival outcomes in patients with early-stage, locally advanced esophageal cancer.

Measuring changes in levels of BCR-ABL in patients with chronic myeloid leukemia (CML) can help predict treatment outcomes and disease progression, according to a new study.

A phase III trial of the insulin-like growth factor 1 receptor inhibitor figitumumab showed no benefit in survival outcomes when added to standard chemotherapy in patients with advanced non–small-cell lung cancer.

A novel inhibitor of CD19 was well tolerated and showed promising activity in patients with relapsed or refractory B-lineage non-Hodgkin lymphoma, according to a phase I study.

Cisplatin, etoposide, and irinotecan outperformed topotecan as second-line chemotherapy in patients with sensitive relapsed small-cell lung cancer (SCLC) in a Japanese trial, though there was substantially increased toxicity with the regimen.

The addition of ramucirumab to docetaxel improved outcomes over placebo with docetaxel as a second-line treatment of patients with advanced non-small-cell lung cancer (NSCLC), according to results of the REVEL trial.

Preoperative staging of esophageal cancer with PET/MR is approximately as good as with endoscopic ultrasound, and may improve slightly over ultrasound and PET/CT scans, according to a new study.

Searching for and eradicating the bacteria Helicobacter pylori could reduce the incidence of gastric cancer in otherwise healthy individuals, especially in Asian populations, according to a new study.

A pooled analysis of three prospective trials showed that post-induction therapy PET-CT scans are highly predictive of progression-free and overall survival in follicular lymphoma patients.
Ruxolitinib was significantly better than the best available therapy in a phase III, open-label trial of patients with polycythemia vera who were resistant to or intolerant of hydroxyurea.

A phase II trial of the selective spleen tyrosine kinase (Syk) inhibitor GS-9973 showed substantial biologic activity in patients with chronic lymphocytic leukemia (CLL).

The addition of the anti-EGFR antibody necitumumab to gemcitabine-cisplatin chemotherapy resulted in a modest but significant benefit to patients with stage IV squamous cell non-small-cell lung cancer, according to results of the SQUIRE study presented at ASCO.

The addition of bevacizumab to erlotinib as first-line therapy yielded a significantly extended progression-free survival in patients with advanced EGFR-mutation-positive non-small-cell lung cancer (NSCLC), according to a new phase II study.

Ibrutinib substantially increased progression-free survival and overall survival over ofatumumab in patients with chronic lymphocytic leukemia (CLL) and small lymphocytic lymphoma (SLL), according to the results of the RESONATE trial.

Thoracic radiotherapy along with prophylactic cranial irradiation (PCI) significantly prolonged progression-free and overall survival in patients with extensive-stage small-cell lung cancer, according to results of a new study presented at ASCO.

Treatment with lenalidomide and dexamethasone improved quality-of-life measures in multiple myeloma patients, according to a study presented at the 2014 ASCO Annual Meeting.

The addition of the MET-targeting antibody onartuzumab to erlotinib added no benefit, and may have been detrimental, to patients with MET-amplified stage IIIb/IV metastatic non–small-cell lung cancer, according to a new phase III trial.

Continuous therapy produces drastically better progression-free survival and overall survival outcomes in patients with multiple myeloma. A novel endpoint involving time to second progression is an important tool in evaluating this type of treatment in the future.

Expression of the p16 tumor suppressor was found to be a prognostic factor for survival in patients with carcinoma of the anal canal.

Implementation of a national lung cancer screening program using low-dose CT will identify almost 55,000 additional lung cancer cases over 5 years, but will add $9.3 billion to Medicare expenditures.

A novel agent known as AZD9291 showed promising results in a phase I dose escalation trial among non-small-cell lung cancer (NSCLC) patients whose disease progresses after treatment with EGFR-targeting tyrosine kinase inhibitors.

The new drug volasertib, which is in trials for the treatment of patients with acute myeloid leukemia (AML), has been granted orphan drug designation by the FDA.

Modafinil, which is commonly prescribed to manage fatigue in cancer patients, had no effect on fatigue in a new study of patients with non-small-cell lung cancer.

Obesity or underweight status at diagnosis can influence outcomes in pediatric ALL patients, but a new study shows that the risk can be mitigated if weight status changes following treatment induction.

A novel agent known as BL-8040 will enter phase I/II testing for the treatment of chronic myeloid leukemia, according to BioLineRx, the company developing the drug.

A rare subtype of disease known as atypical chronic myeloid leukemia (aCML) has been shown to be clinically distinct from a related condition known as unclassifiable myelodysplastic/myeloproliferative neoplasm.